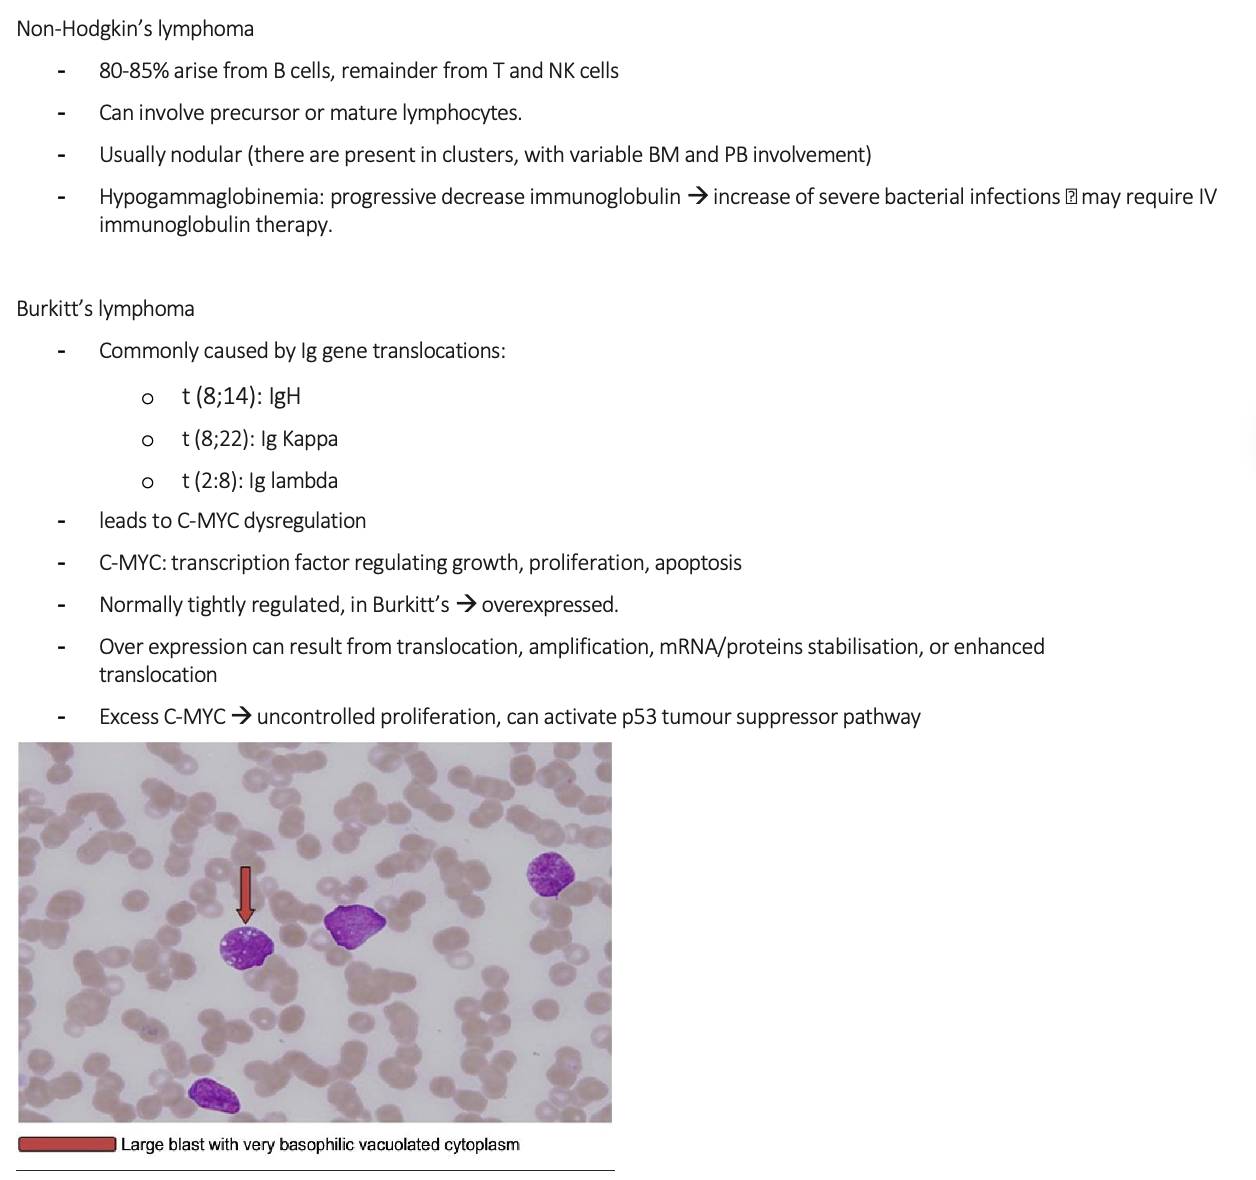

Morphology notes
1/43
There's no tags or description
Looks like no tags are added yet.
Name | Mastery | Learn | Test | Matching | Spaced |
|---|
No study sessions yet.
44 Terms
Name the possible symptoms of MAHA
- Fatigue, weakness, pallor, jaundice, and haemoglobinuria: these are all classic symptoms of haemolytic anaemia. The destruction of the red blood cell leads to low RBC count (anaemia), which causes fatigue and pallor due to lack of O2 carrying capacity. The breakdown of haemoglobin from the destroyed red cells releases bilirubin, which the body can’t process fast enough, leading to jaundice (yellowing of the skin and eyes) and the presence of haemoglobin in the urine (haemoglobinuria).
- Thrombocytopenia: This is a key feature of MAHA, especially in TTP, HUS, and DIC. The platelets are consumed in the formation of the microscopic clots, leading to a low platelet count. This is why patients can also have bleeding symptoms.
- Kidney and Neurological Issues: These issues arise from the tiny clots blocking blood flow to critical organs. The kidneys are particularly susceptible, as their small blood vessels become occluded, leading to renal failure (a prominent feature of HUS). Similarly, clots in the small vessels of the brain can cause neurological symptoms like confusion, seizures, or stroke (more common in TTP).
Name the possible morphology for MAHA
RBC – anisocytosis, schistocytes (helmet or triangular cells), moderate polychromasia, reticulocytes, crenated/burr cells. WBC – neutrophilia, moderate left shift, and toxic granulation. PLT – thrombocytopenia with occasional giant platelets
What are the DD for MAHA and the further tests
Differential Diagnosis: TTP, HUS, DIC.
Further Tests:
Confirmation of provisional diagnosis
- Chemistries Increased LDH & Bili decreased Haptoglobin.
- DAT negative (helps exclude autoimmune haemolysis)
Exclusion of differential diagnosis
- ADAMTS13 activity normal excludes TTP.
- Stool culture/PCR Shiga toxin producing E. coli (in D+ HUS) negative exclude HUS
- Complement studies negative excludes D-HUS
- Coagulation profile exclude DIC
Explain the pathophysiology of MAHA
Mechanism
- Cause: Predominantly due to mechanical damage to red blood cells.
- Process:
o RBCs are forced through narrowed blood vessels partially obstructed by microthrombi
o The shear stress and trauma cause fragmentation of RBCs
o Leads to the formation of schistocytes (fragmented RBCs seen on blood smear).
Underlying Cause of Microthrombi
- Endothelial cell injury.
- Activation of the coagulation cascade.
- Results in the formation of platelet-rich microthrombi within the microvasculature.
Treatment
- Treatment is directed at the underlying cause
List three common clinical features of Hemolytic Uremic Syndrome (HUS) and briefly explain their pathophysiological basis.
- Weakness: This is a symptom of haemolytic anaemia. The small clots physically damage and destroy red blood cells as they pass through the small blood vessels, leading to a shortage of oxygen-carrying cells and causing weakness and fatigue.
- Purpura: This is a symptom of thrombocytopenia. Platelets are consumed in the formation of the microthrombi, leading to a low platelet count and, consequently, bleeding into the skin and easy bruising.
- Gastroenteritis & Diarrhea: In the most common form of HUS (typical HUS), the syndrome is triggered by an infection, usually with a toxin-producing bacteria like E. coli. The infection causes gastroenteritis, leading to abdominal pain and often bloody diarrhea, which precedes the other HUS symptoms. The toxin enters the bloodstream from the gut and initiates the process of microthrombi formation.
Identify the possible morphology for HUS
Possible Morphology: RBC - Marked anisocytosis, moderate polychromasia, marked fragments, marked crenated cells, mild spherocytes, marked acanthocytes & occasional nRBC. WBC - Marked neutrophilia, mild lymphocytosis, mild reactive lymphocytes, moderate monocytosis & mild left shift. PLT – thrombocytopenia with occasional giant platelets.
What are the differential diagnosis of HUS and the furthers tests/expected results
Differential Diagnosis: Idiopathic thrombocytopenic purpura, DIC, TTP, Sepsis/bacterial, Haemolysins elevated liver enzyme and low platelets (HELLP), Drug-induced thrombocytopenia.
Further Tests:
Confirmation of the provisional diagnosis
- Chemistries Increased LDH and indirect bilirubin
- Decreased haptoglobin
- RFT increased creatinine urea, proteinuria, and haematuria.
- ADAMTS13 normal or mildly reduced (excludes TTP)
- Stool culture and Shiga toxin PCR/ELISA confirms D+ HUS
Exclusion of differential diagnosis
- Coagulation profile normal excludes DIC.
- Blood Culture normal exclude sepsis/bacterial infection.
- Toxicology screening normal excludes drug induced thrombocytopenia
Explain the pathophysiology of HUS
Pathophysiology:
- Belongs to Thrombotic Microangiopathies (TMA).
Key Features of TMA
- Widespread occlusive microvascular thromboses.
- Leads to:
o Thrombocytopenia (due to platelet consumption).
o MAHA
o End-organ ischemia (variable symptoms depending on organ affected).
Types of HUS
D+ HUS (Typical HUS)
Accounts for ~95% of cases in children.
Preceded by diarrhoea (usually bloody).
Most common cause: Shiga-toxin producing Escherichia coli (STEC).
E. coli serotype O157:H7 responsible for >80% of infections.
Pathogenesis
Shiga toxin:
Crosses gastrointestinal mucosa into circulation.
Preferentially localizes to kidneys.
Inhibits protein synthesis → cell necrosis/apoptosis.
Endothelial injury → renal microvascular thrombosis via coagulation activation.
Platelet aggregation → consumptive thrombocytopenia.
RBCs mechanically damaged in occluded vessels → microangiopathic haemolytic anaemia.
D- HUS (Atypical HUS)
Accounts for ~5% of cases.
Not preceded by diarrhoea or gastrointestinal infection.
More variable in aetiology, age of onset, and clinical presentation.
Pathogenesis
- Associated with complement dysregulation in ~50% of cases.
- Genetic and acquired causes:
o Mutations in complement regulatory proteins:
§ Factor H
§ Factor I
§ Factor B
§ Autoantibodies against Factor H.
o Result: Failure to suppress complement activation.
o Glomerular endothelium is particularly vulnerable → microvascular injury.
What would the treatment plan be for HUS
- Typical HUS (STEC-HUS): Supportive Care (mainstay of treatment). Fluid/electrolyte management, blood pressure control, and dialysis if needed. Avoid antibiotics and platelet transfusions (unless severe bleeding).
- Atypical HUS: Complement Inhibitors (e.g., Eculizumab, Rovelizumab) to block complement system over-activation. Supportive care and dialysis are also used.
What is the treatment plan for immune thrombocytopenic purpura
- Rescue Therapy (for severe/life-threatening bleeding): High-dose IVIG, high-dose corticosteroids, and/or rapid platelet transfusions.
Explain the pathophysiology for ITP
Nature of disease: Primarily an autoimmune disorder.
Mechanism
The immune system mistakenly identifies platelets as foreign.
Produces IgG antibodies that bind to platelets.
Antibody-coated platelets are destroyed in the spleen and liver.
Results in decreased platelet count (thrombocytopenia).
Triggers:
Not fully understood.
Possible contributing factors:
Genetic predisposition
Certain infections
Certain medications
Clinical Management
Mild cases: Patients with no bleeding and a not-too-low platelet count may not require treatment.
Moderate to severe cases: Medications to increase platelet count and splenectomy.
Identify the differential diagnosis of ITP and the further tests/expected results
Differential Diagnosis: TTP, HUS, DIC, Drug induced thrombocytopenia, infections, MDS, LPD, and PNH leading to haemolytic anaemia and thrombocytopenia.
Confirmation of provision diagnosis
- BM biopsy to rule out other conditions (BM will show normal or increased number of megakaryocytes in ITP)
- Antiplatelet antibodies (though not always conclusive),
- DAT (can be positive in ITP).
Exclusion of differential diagnosis
- ADAMTS-13 activity normal excludes TTP
- Stool culture/PCR and RFT normal excludes HUS
- Coagulation profile normal excludes DIC
- Toxicology screen normal exclude Drug induced thrombocytopenia
- Viral serology and blood cultures negative rule out infections
- Cytogenetics negative for del 5q, del 7q or monosomy 7, del 20q and trisomy 8 rules out MDS
- Flow cytometry negative for clonal B or T cells or normal CD55 and CD59 on RBCs excludes lymphoma and PNH.
What is the possible morphology for ITP
Possible Morphology: RBC – schistocytes. WBC – normal in number and morphology. PLT - giant platelets, thrombocytopenia
Name the possible symptoms of ITP and explain the pathophysiology of these symptoms
- Fatigue: This symptom is often a result of anaemia that develops from chronic, low-grade bleeding (even if not visible). When you lose red blood cells over time, your body's ability to carry oxygen is reduced, leading to fatigue and weakness.
- Easy Bruising, Petechiae, Purpura: These are all signs of bleeding into the skin. Platelets are the first responders to small vessel damage. When there aren't enough, even the most minor trauma (or no trauma at all) can cause blood to leak out of the tiny capillaries under the skin. Petechiae are pinpoint-sized leaks, while purpura are larger, purplish bruises.
- Bleeding from Gums or Nose: The mucous membranes in your mouth and nose are rich in small, fragile blood vessels. Without enough platelets to seal these vessels, spontaneous bleeding can occur.
- Blood in Urine and Stool: A low platelet count can lead to internal bleeding in the urinary or gastrointestinal tracts. This can manifest as blood in the urine (haematuria) or stool (melena or hematochezia).
Explain the treatment plan for TTP
- Plasma Exchange (PEX): Must be started immediately upon suspicion, before ADAMTS13 results are available. It removes the autoantibodies that inhibit ADAMTS13 and replaces the deficient ADAMTS13 enzyme.
- Caplacizumab: A critical new therapy that provides a rapid blockade of microclot formation while PEX and immunosuppression work to fix the underlying cause.
Explain the pathophysiology of TTP
Core feature:
Characterized by microangiopathic haemolysis and platelet aggregation/hyaline thrombi.
Thrombus formation is unrelated to coagulation system activity.
Thrombi features:
Predominantly platelet-rich microthrombi.
Form mainly in the microcirculation (arterioles, capillaries)
Cause partial vascular occlusion.
Endothelial proliferation occurs overlying thrombi.
Consequences:
Organ ischemia
Thrombocytopenia
Erythrocyte fragmentation → schistocytes
No inflammatory changes.
Organs Affected
Highly vulnerable: Kidneys, brain, heart, pancreas, spleen and adrenal glands
Affected to a lesser extent: Liver, lungs, GIT, gallbladder, skeletal muscles, retina, pituitary gland, ovaries, uterus, and testes.
Role of von Willebrand Factor (vWF)
Large adhesive glycoprotein that mediates thrombus formation at vascular injury sites.
Synthesized in endothelium and megakaryocytes.
Circulates in plasma as multimers of varying size.
ULVWF (Ultra large vWF multimers):
The largest soluble protein in human plasma.
Secreted from endothelium.
Most active form of vWF → major pathogenic factor in TTP.
Greater ability to bind platelets and mediate thrombus formation.
Accumulate in arterioles and capillaries under high shear stress.
Cause endothelial injury, platelet clumping, and ischemia.
Impact on red blood cells:
RBCs collide with thrombi → fragmentation → haemorrhage.
leads to formation of schistocytes due to the occluded vessels
Endothelial Cell Role
activated endothelial cells are the main source of ULVWF secretion
ULVWF multimers:
Bind to platelet surface receptors.
Adhere to damaged endothelium or exposed sub endothelium.
High shear stress → Favors thrombus formation rather than proteolysis of ULVWF.
Regulation by ADAMTS-13
Metalloprotease with multiple domains.
Major regulator of vWF size in plasma.
Cleaves ULVWF multimers as they are secreted from endothelial cells.
Prevents excessive platelet aggregation and microthrombi formation.
Types of TTP
Acquired TTP
Caused by autoantibodies against ADAMTS-13.
These antibodies inhibit ADAMTS-13 activity, preventing ULVWF cleavage.
Congenital (Familial) TTP
Due to mutations in the ADAMTS-13 gene.
Leads to inactivation or decreased activity of ADAMTS-13.
Identify the differential diagnosis and the further tests/expected results for TTP

Identify the possible morphology for TTP
Possible Morphology: RBC - Moderate anisocytosis, moderate polychromasia, moderate hypochromic, mild fragments & marked crenated cells. WBC - Mild leucocytosis marked neutrophilia with mild toxic granulation. PLT – marked thrombocytopenia with normal morphology
Name the possible symptoms associated with ITP
- Anaemia (fatigue, weakness): as red blood cells try to squeeze through the narrowed, clot-filled, they are physically sheared and destroyed. This process is called MAHA. The rapid destruction of red blood cells leads to a low RBC count, causing the fatigue and weakness associated with anaemia.
- GI bleeding: the low platelet count is a result of platelets being consumed to form the microthrombi. With a severely reduced number of circulating platelets, the blood can’t clot properly. This leads to spontaneous bleeding, including into the GI tract, causing symptoms like black or bloody stools.
- Headache, hypertension and confusion: the microthrombi can block blood flow to the brain, leading to ischaemia. This cerebral ischaemia is responsible for the neurological symptoms of TTP, including headaches and confusion. The widespread blockage of blood vessels can also contribute to high blood pressure.
- Fever: while the exact mechanism is not fully understood, fever is a classic component of the TTP pentad. It is thought to be a result of the inflammatory response triggered by the widespread microvascular damage and tissue ischemia
Explain the pathophysiology for Myeloma

Identify the differential diagnosis for myeloma and FTs/ERs

Possible symptoms for myeloma

Pathophysiology for mantle cell lymphoma

DD, FT/ER for mantle cell lymphoma

Possible symptoms for MCL

Pathophysiology for Burkitt’s lymphoma